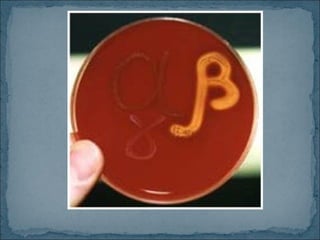

Este documento describe las características de varios géneros y especies de estreptococos. Los estreptococos son cocos Gram positivos que se encuentran comúnmente en la piel y mucosas humanas y animales. El S. pyogenes del grupo A es el principal patógeno humano y causa infecciones como faringoamigdalitis, impétigo y erisipela. El S. agalactiae del grupo B puede causar sepsis y meningitis neonatal. Los enterococos como E. faecalis y E. faecium son causas frecuentes de infe